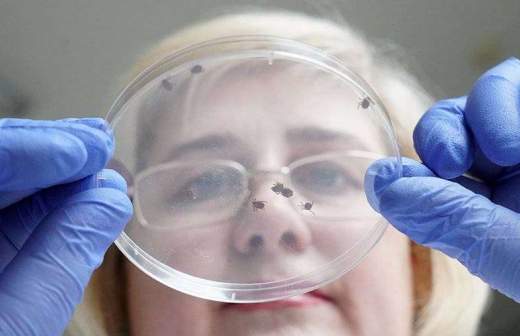

Три случая клещевого энцефалита выявили в Приморье
В Приморском крае более 4 тыс. человек пострадали в результате укусов клещей. Медики сообщают о случаях энцефалита, боррелиоза и риккетсиоза.
По данным Роспотребнадзора, на экспертизу было сдано порядка 2,7 тыс. клещей. В 587 из них обнаружены возбудители различных заболеваний. У трех человек врачи диагностировали клещевой энцефалит. Они были укушены клещами на территории Ольгинского и Надеждинского районов при работе на даче или сборе дикоросов. Об этом сообщает ИА PrimaMedia.
У 28 человек выявили клещевой боррелиоз, в их числе шесть детей. У жителя Владивостока диагностировали клещевой рикетсиоз.
Медики напоминают, что при укусе клеща необходимо быстро удалить вредителя, для этого желательно обратиться в поликлинику.